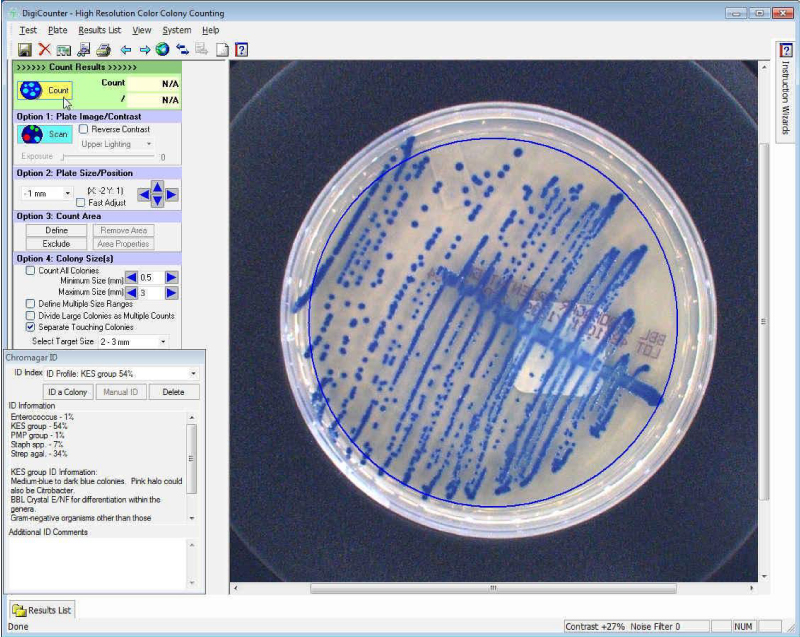

В комплекте с программным модулем подсчета колоний анализатор BIOMIC V3 автоматически подсчитывает колонии бактерий, дрожжей и плесени, а также анализы вирусных бляшек на чашках с агаром с помощью технологии анализа цветного цифрового изображения.
Прибор может считывать различные типы и размеры тестов, включая: чашки диаметром до 150 мм, квадратные чашки, 3M™ Petrifilm™, анализы Эймса, анализы фагов/бляшек, заливные чашки, спиральные посевы, фильтрующие мембранные агаровые чашки и хромогенные агары.
Благодаря закрытой камере 5 МП с верхним и нижним LED освещением яркого и темного поля прибор может считывать прозрачный, непрозрачный, кровяной и темный агар.
Прибор может считывать всю чашку, половину, квадранты или пользовательские зоны. Каждый сегмент чашки подсчитывается отдельно в дополнение к общему количеству чашек.
Колонии, которые соприкасаются или перекрываются, можно автоматически разделить по размеру и форме. Эти настройки можно включать или выключать. Колонии также можно добавить вручную или удалить из автоматического подсчета.
Наименьшая колония, которую можно обнаружить, составляет 0,05 мм, а наименьшая дискриминация размера колонии составляет 0,08 мм.
Колонии можно дифференцировать по размерам. Одновременно можно определить и подсчитать до 10 диапазонов размеров.
Прибор улучшает последовательность, точность и скорость считывания по сравнению с ручным выполнением. Это экономит 99% времени анализа, устраняет ошибки считывания и интерпретации и сокращает время обучения.
На экране предоставляется увеличенное изображение каждой исследовательской чашки для просмотра микробиологом и редактирования при необходимости. Изображения и результаты тестов сохраняются для дальнейшего просмотра.